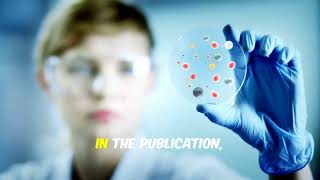

Groundbreaking Research with Neuromics Pancreatic CAFs video
Online izle ve mp4 mp3 formatlarinda yukle

Videonun muddeti: 0:57
Groundbreaking Research with Neuromics Pancreatic CAFs videosu mp4 ve mp3 yuklemek ucun hazirdir
Diqqet! Siz Mp4 yukle ve ya Mp3 yukle duymesine basdiqdan sonra eger sistem sizi reklam sehifesine atarsa o zaman derhal geri qayidib emeliyyati tekrar edin ve faylin yuklemek ucun hazir olmasini gozleyin
Videodan Mp4 Yukle
Videodan Mp3 Yukle-1
Videodan Mp3 Yukle-2
Oxshar Axtarishlar
 Groundbreaking Research with Neuromics Pancreatic CAFs
Groundbreaking Research with Neuromics Pancreatic CAFs Cancer Research Thrives with Neuromics Human Cells
Cancer Research Thrives with Neuromics Human Cells Human Cells for Cancer Research
Human Cells for Cancer Research The future of pancreatic cancer treatment
The future of pancreatic cancer treatment Pancreas Cancer Breakthrough - In depth
Pancreas Cancer Breakthrough - In depth Artificial Intelligence New Research Teams (AI) | Pancreatic Cancer Collective
Artificial Intelligence New Research Teams (AI) | Pancreatic Cancer Collective CD9 identifies pancreatic cancer stem cells and modulates glutamine metabolism to fuel tumour growth
CD9 identifies pancreatic cancer stem cells and modulates glutamine metabolism to fuel tumour growth Current and Future Directions in Metastatic Pancreatic Cancer
Current and Future Directions in Metastatic Pancreatic Cancer Pancreas Cancer: Diagnosis and Current Treatment Approaches by Nathan Bahary, MD, PhD
Pancreas Cancer: Diagnosis and Current Treatment Approaches by Nathan Bahary, MD, PhD
Video Mp4 Mp3Azwap.Biz
Azwap.Biz 2021-2023

Groundbreaking Research with Neuromics Pancreatic CAFs
Groundbreaking Research with Neuromics Pancreatic CAFs Cancer Research Thrives with Neuromics Human Cells
Cancer Research Thrives with Neuromics Human Cells Human Cells for Cancer Research
Human Cells for Cancer Research The future of pancreatic cancer treatment
The future of pancreatic cancer treatment Pancreas Cancer Breakthrough - In depth
Pancreas Cancer Breakthrough - In depth Artificial Intelligence New Research Teams (AI) | Pancreatic Cancer Collective
Artificial Intelligence New Research Teams (AI) | Pancreatic Cancer Collective CD9 identifies pancreatic cancer stem cells and modulates glutamine metabolism to fuel tumour growth
CD9 identifies pancreatic cancer stem cells and modulates glutamine metabolism to fuel tumour growth Current and Future Directions in Metastatic Pancreatic Cancer
Current and Future Directions in Metastatic Pancreatic Cancer Pancreas Cancer: Diagnosis and Current Treatment Approaches by Nathan Bahary, MD, PhD
Pancreas Cancer: Diagnosis and Current Treatment Approaches by Nathan Bahary, MD, PhD